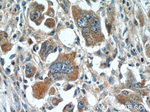
WDR16 Antibody in Immunohistochemistry (Paraffin) (IHC (P))

Search
Proteintech
WDR16 Polyclonal Antibody
{{$productOrderCtrl.translations['antibody.pdp.commerceCard.promotion.promotions']}}
{{$productOrderCtrl.translations['antibody.pdp.commerceCard.promotion.viewpromo']}}
{{$productOrderCtrl.translations['antibody.pdp.commerceCard.promotion.promocode']}}: {{promo.promoCode}} {{promo.promoTitle}} {{promo.promoDescription}}. {{$productOrderCtrl.translations['antibody.pdp.commerceCard.promotion.learnmore']}}
产品信息
12644-1-AP
种属反应
宿主/亚型
分类
类型
抗原
偶联物
形式
浓度
规格
纯化类型
保存液
内含物
保存条件
运输条件
产品详细信息
Immunogen sequence: GEGHQFLVG TEESHIYRVS FTDFKETLIA TCHFDAVKDI VFPFGTAELF ATCAKKDIRV WHTSSNRELL RITVPNMTCH GIDFMRDGKS IISAWNDGKI RAFAPETGRL MYVINNAHRI GVTAIATTSD CKRVISGGGE GEVRVWQIGC QTQKLEEALK EHKSSVSCIR VKRNNEECVT ASTDGTCIIW DLVRLRRNQM ILANTLFQCV CYHPEEFQII TSGTDRKIAY WEVFDGTVIR ELEGSLSGSI NGMDITQEGV HFVTGGNDHL VKVWDYNEGE VTHVGVGHSG NITRIRISPG NQYIVSVSAD GAILRWKYPY TS (300-620 aa encoded by BC025392)
靶标信息
WD repeat-containing proteins, such as WDR16, play crucial roles in a wide range of physiologic functions, including signal transduction, RNA processing, remodeling the cytoskeleton, regulation of vesicular traffic, and cell division (Silva et al., 2005 ).
仅用于科研。不用于诊断过程。未经明确授权不得转售。
篇参考文献 (0)
生物信息学
蛋白别名: Cilia- and flagella-associated protein 52; unnamed protein product; WD repeat domain 16; WD repeat-containing protein 16; WD40-repeat protein up-regulated in HCC; WD40-repeat protein upregulated in HCC
基因别名: CFAP52; HTX10; WDR16; WDRPUH
UniProt ID: (Human) Q8N1V2
Entrez Gene ID: (Human) 146845